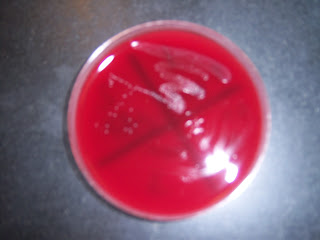

LAB- turned in defined words and turned in out of class assignment
-MacConkey experiment
(-) S. aureus
(-) E. faecalis
(+) E. coli: hott pink
(-) S. enteritidis
-CNA (isolation streak) experiment
E. coli
(+) E. faecalis
(+) S. enteritidis
-PEA (isolation streak) experiment
(-) E. coli
E. faecalis
(+) S. aureus
-TSA (sheep's blood) (isolation streak) experiment
(+) S. aureus
(partial) E. faecalis
(partial) S. epi
-motility (stab) experiment
(+) P. vulgaris: spreads
(-) S. epi: just stays in the line
-TSA (plain) (isolation streak) experiment
S. aureus
S. saprophyticus
-EMB experiment
(+) E. coli: green
(-) E. faecalis
(+) S. enteritidis: no color change
(+) E. aerogenes: pink
-Mannitol Salt experiment
(+) S. saprophyticus: yellow, ferment
(+) S. aureus: yellow, ferment
(-) S. epi

No comments:
Post a Comment